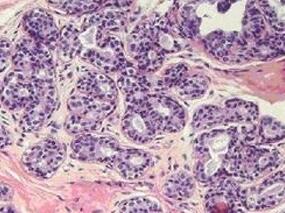
男70岁，怕热、多汗、抑郁、粒细胞减少、房颤

-
男57岁,高血糖十年,左下肢放射痛1月余,加重10天
环球医学资讯
2016年11月22日
点击量:509
1小时条评论患者男性,57岁,于2011年8月29日入院。 一、主诉 高血糖10年,左下肢放射痛1月余,加重10天。 二、病史询问 (一)初步诊断思路及问诊目的 患者中年男性,本次入院主因左下肢放射痛。问诊主要围绕着下肢放射痛发生的原因。一般临床出现下肢放射痛主要考虑血管...
-
男56岁,左侧胸肋部、腰部及右下肢疼痛1年
环球医学资讯
2016年11月22日
点击量:320
1小时条评论患者男性,56岁,汉族,职员。 一、主诉 左侧胸肋部、腰部及右下肢疼痛1年。 二、病史询问 (一)初步诊断思路及问诊目的 患者为中年男性,病史较长,以左侧胸肋部,腰部及右下肢疼痛为主诉。肋骨为非承重骨,其发生疼痛时,首先考虑是否存在着骨软化。骨软化患...
-
男59岁,心悸、手抖、消瘦、乏力4个月,双下肢水肿3…
环球医学资讯
2016年11月16日
点击量:285
1小时条评论患者男性,59岁,于2008年2月13日入院。 一、主诉 心悸、手抖、消瘦、乏力4个月,双下肢水肿3个月。 二、病史询问 (一)初步诊断思路及问诊目的 患者有心悸、手抖、消瘦、乏力症状,按常见病优先考虑的原则应将甲状腺功能亢进症放在首位。因此,问诊目的主要围...
-
女34岁,心悸、乏力、怕热、多汗、手颤5年,恶心、…
环球医学资讯
2016年11月16日
点击量:1566
1小时条评论患者女性,34岁,于2006年1月20日入院。 一、主诉 心悸、乏力、怕热、多汗、手颤5年,恶心、纳差3个月。 二、病史询问 (一)初步诊断思路及问诊目的 中年女性,首先心悸、乏力、怕热、多汗、手颤等高代谢症状5年,首先需考虑甲亢的诊断。因此,问诊目的主要围...
-
男54岁,心悸、手抖、消瘦10个月,行走不稳20天,意…
环球医学资讯
2016年11月10日
点击量:269
1小时条评论患者男性,54岁,于2010年3月16日入院。 一、主诉 心悸、手抖、消瘦10个月,行走不稳20天,意识障碍2天。 二、病史询问 (一)初步诊断思路及问诊目的 患者为54岁男性,既往有甲亢和贫血病史,近10个月再次出现心悸、手抖、消瘦,已于门诊诊断为桥本甲状腺炎,...
-
女52岁,发作性饥饿感、心悸、乏力、大汗1个月
环球医学资讯
2016年11月10日
点击量:230
1小时条评论女性,52岁,于2009年10月入院。 一、主诉 发作性饥饿感、心悸、乏力、大汗1个月。 二、病史询问 (一)初步诊断思路和问诊目的 患者为中老年女性,出现发作性饥饿感、心悸、乏力、大汗,这是典型的低血糖临床表现。当然,也不能除外造成上述症状的其他原因,如...
-
维持性血液透析患者合并甲亢一例
环球医学资讯
2016年11月08日
点击量:929
1小时条评论1 病例资料 患者孙某,男性,39岁,因维持性血液透析1+年,纳差伴进行性消瘦2月入院。患者1+年前因终末期肾病(病因不详)开始规律血液透析治疗,每周3次,使用左前臂头静脉-桡动脉内瘘,给予纠正贫血等对症支持治疗。既往无甲亢、甲减病史,无心脏及肺部慢性病史,...
-
女66岁,怕热、多汗、心悸、手颤半年,加重伴胸闷气…
环球医学资讯
2016年11月04日
点击量:1841
1小时条评论患者,女性,66岁,于2012年2月27日住院。 一、主诉 怕热、多汗、心悸、手颤半年,加重伴胸闷、气短、双下肢水肿1个月。 二、病史询问 (一)初步诊断思路及问诊目的 患者主诉为怕热、多汗、心悸、手颤半年,加重伴胸闷、气短、双下肢水肿1个月。诊断思路应遵循...
-
男70岁,怕热、多汗、抑郁、粒细胞减少、房颤
环球医学资讯
2016年11月04日
点击量:306
1小时条评论患者男性,70岁,于2007年11月28日住院。 一、主诉 怕热、多汗、心悸、手颤伴乏力、纳差1年,加重20天。 二、病史询问 (一)初步诊断思路及问诊目的 患者主诉怕热、多汗、心悸、乏力,首先应该围绕甲亢去思考和询问。甲亢的表现有很大异质性,多数与自身免疫有...
-
女58岁,尿频、全身骨痛10月余
环球医学资讯
2016年10月31日
点击量:484
1小时条评论患者女性,58岁,于2010年10月8日入院。 一、主诉 尿频9年,全身骨痛10月余。 二、病史询问 (一)初步诊断思路及问诊目的 患者的主诉为尿频和骨痛。应该注意是否出现多尿、夜尿和口渴等症状,有无反复发作泌尿系结石;骨痛应注意有无自发或受外力的骨折,是否...

会员登录

